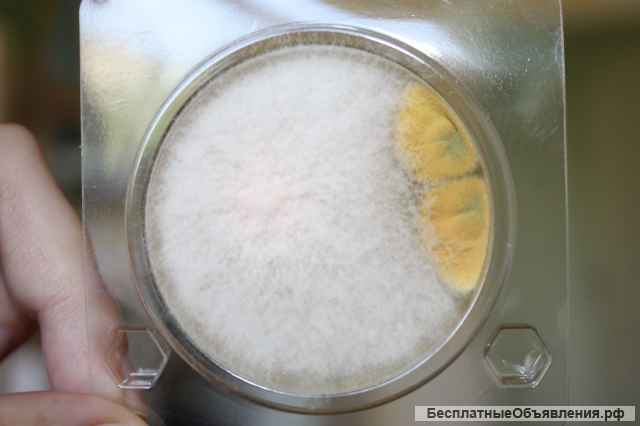
Экспресс тест на определение E.coli и колиформные бактерии

Экспресс тест на определение E.coli и колиформные бактерии
Замена для 3М Petrifilm 6421 Тест-пластины для определ кол-ва энтеробактерий.
Готовые тест пластины для анализа сырья, полуфабрикатов, готовых продуктов питания, окружающей среды и пр. Тщательный биоконтроль на вашем производстве.
- Соответствуют требованиям действующего санитарного законодательства РФ
- Удобство подсчета колоний.
- Соответствует классическим методам исследований.
- Результаты через 24 часа.
Петритест - это российский аналог таких тест-систем, как
Дипслайд, Petrifilm, RIDA COUNT, Oxoid, Orion Diagnostica, Schülke & Mayr, Merck Millipore, Singlepath, Duopath, MVP ICON, HY-RiSE, Envirocheck Dip Slides, MC-Media Pads , Sampler, HYCON Contact SlidesQuant
По своему функционалу, стоимости и удобству применения Петритест заметно выделяется среди известных зарубежных производителей.
Экономьте ресурсы и получайте самый лучший результат вместе с Петритест.
Готовые тест пластины для анализа сырья, полуфабрикатов, готовых продуктов питания, окружающей среды и пр. Тщательный биоконтроль на вашем производстве.
- Соответствуют требованиям действующего санитарного законодательства РФ
- Удобство подсчета колоний.
- Соответствует классическим методам исследований.
- Результаты через 24 часа.
Петритест - это российский аналог таких тест-систем, как
Дипслайд, Petrifilm, RIDA COUNT, Oxoid, Orion Diagnostica, Schülke & Mayr, Merck Millipore, Singlepath, Duopath, MVP ICON, HY-RiSE, Envirocheck Dip Slides, MC-Media Pads , Sampler, HYCON Contact SlidesQuant
По своему функционалу, стоимости и удобству применения Петритест заметно выделяется среди известных зарубежных производителей.
Экономьте ресурсы и получайте самый лучший результат вместе с Петритест.
| Цена: |
1 700 руб
|
| Город: |
Саратов
|
| Тип: | Продаю |
| Автор: |
|
Регистрация с 05.04.2023 
|
|
| Сайт: | petritest.ru/petritest-smyv |
| Дата: | 10.04.2023 14:47 |
| Номер: | 2581787 |
Сделать объявление:
Ссылка на это объявление:
Похожие объявления

Игрософт 16 в 1 игровой слот автомат
130 000 руб
05.06.2026

Выездная очистка масел
Без цены
02.06.2026

Куплю радиостанции и радиоприёмники СССР: Виола, Ангара, Днепр, Р-159, Р-107м, Р-250, Р-155, Р399А
Без цены
17.11.2025

Подшипник 7226-B-MP-UA производства FAG
15 000 руб
02.06.2026

Опоры трубопроводов
500 руб
24.12.2024

Фильтрация масел
100 руб
02.06.2026

Шарнирная головка SI08T/K
150 руб
02.06.2026

Купим дорого радиодетали СССР: Конденсаторы, микросхемы, транзисторы, реле, переключатели, платы
Без цены
17.11.2025

Ролик крыши 55.3367
320 руб
02.06.2026

Газорегуляторные пункты ГРПШ-02-2У1, ГРПШ-03М-2У1, ГРПШ-03БМ-2У1, ГРПН-300-2У1
146 000 руб
01.06.2026

Газорегуляторные пункты блочные ПГБ-13-2НУ1, ПГБ-13-2ВУ1, ПГБ-50
610 000 руб
01.06.2026

Экспресс-тест на определение Стрептококка (петритест)
1 900 руб
15.04.2023

Куплю радиодетали приборы ссср
Без цены
27.02.2024

Подшипник 29236-E1-MB производитель FAG
50 000 руб
02.06.2026

Система Домашней Автоматизации TELETASK (Умный Дом)
250 000 руб
05.06.2026

Шарнирная головка SI10 T/K
210 руб
02.06.2026

Газорегуляторные пункты ГРПШ, ШГРП, ШРП, ПРДГ, ГРПБ, ПГБ, ГСГО, ГРПН, ГРП, УГРШ
136 000 руб
01.06.2026

Производство электротехнического оборудования
Без цены
15.09.2025

Газорегуляторные пункты ГРПШ-10, ГРПШ-10МС
30 600 руб
01.06.2026

Подшипник 1314 CRAFT
1 200 руб
02.06.2026

Газорегуляторные пункты ГРПШ-04-2У1, ГРПШ-05-2У1, ГРПШ-07-2У1, ГРПН-300-01
136 000 руб
01.06.2026

Шар 20,638 гост 3722-81 шх15
18 руб
02.06.2026

Ручной станок для намотки статаорных обмоток двигателя
500 руб
28.03.2026

Фильтроэлементы очистки тонкой и грубой масла и топлива
100 руб
21.05.2025

Подшипник 7318-B-MP-UA производства FAG
7 000 руб
02.06.2026

Газорегуляторные пункты блочные ПГБ-02-2У1, ПГБ-04-2У1, ПГБ-05-2У1, ПГБ-07-2У1
490 000 руб
01.06.2026

Круглый корпус подшипника в сборе UCFC204 вал 20 мм
420 руб
02.06.2026

Игровые слот-автоматы egt оригинальные
750 000 руб
05.06.2026

Земснаряд Ахтарец 1400 / 40 дизельный, гидро. ЗМК
33 300 000 руб
02.11.2025

Подшипники
1 000 руб
05.03.2024

В продаже игровые автоматы ИГРОСОФТ 16 в 1.Хорошее состояние, купюроприемник, сенсорный монитор Для личного, домашнего использования Отправк...